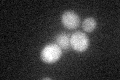
YBR133C

View description
Protein arginine N-methyltransferase that exhibits septin and Hsl1p-dependent bud neck localization and periodic Hsl1p-dependent phosphorylation; required along with Hsl1p for bud neck recruitment, phosphorylation, and degradation of Swe1p
Localization:
Intensity:
Fold change:
Significance:
-
C’ GFP library in SD

below threshold16.41 -
N' NOP1pr-GFP in SD

N/A0 -
N' TEF2pr-mCherry in SD

N/A0 -
N' NATIVEpr-GFP in SD

N/A0 -
N' TEF2pr-VC and Cyto-VN in SD

N/A0 -
C’ GFP library in SD+DTT
cytosol15.730.95No -
C’ GFP library in SD+H2O2

cytosol15.550.94No -
C’ GFP library in Starvation Media

cytosol13.630.83No -
C’ GFP library on the background of Pup2-DaMP

below threshold -
C’ GFP library on the background of CCT mutant

below threshold17.28391.05303No
